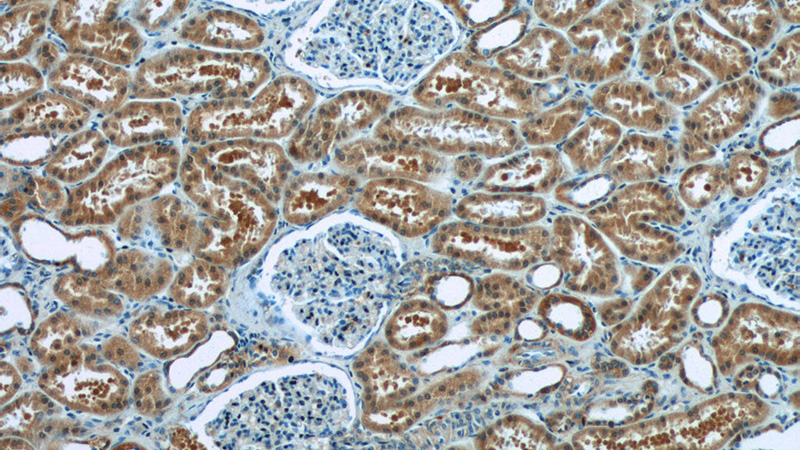
Immunohistochemistry of paraffin-embedded human kidney tissue slide using Catalog No:108365(BAX Antibody) at dilution of 1:50 (under 10x lens)
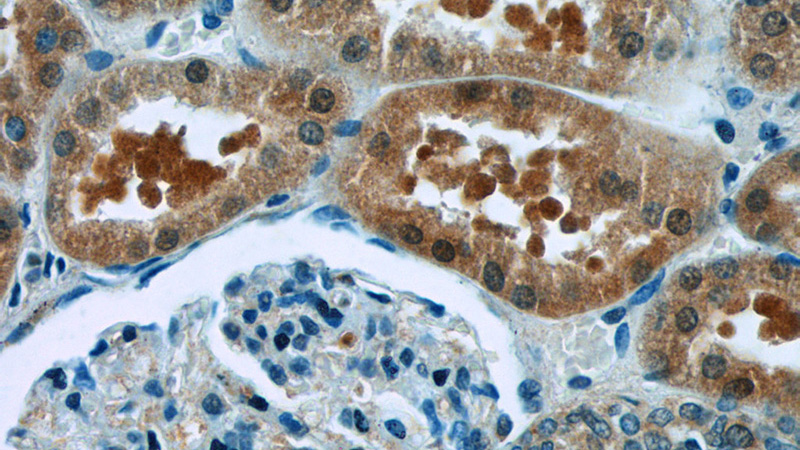
Immunohistochemistry of paraffin-embedded human kidney tissue slide using Catalog No:108365(BAX Antibody) at dilution of 1:50 (under 40x lens)

-
Product Name
BAX antibody
- Documents
-
Description
BAX Rabbit Polyclonal antibody. Positive WB detected in HEK-293 cells, COLO 320 cells, COS-7 cells, HeLa cells, MCF7 cells, RAW264.7 cells. Positive IP detected in HEK-293 cells. Positive IHC detected in human kidney tissue, human breast cancer tissue. Observed molecular weight by Western-blot: 21 kDa
-
Tested applications
ELISA, WB, IHC, IP
-
Species reactivity
Human, Mouse, Monkey; other species not tested.
-
Alternative names
Apoptosis regulator BAX antibody; BAX antibody
-
Isotype
Rabbit IgG
-
Preparation
This antibody was obtained by immunization of BAX recombinant protein (Accession Number: NM_138761). Purification method: Antigen affinity purified.
-
Clonality
Polyclonal
-
Formulation
PBS with 0.02% sodium azide and 50% glycerol pH 7.3.
-
Storage instructions
Store at -20℃. DO NOT ALIQUOT
-
Applications
Recommended Dilution:
WB: 1:500-1:5000
IP: 1:500-1:5000
IHC: 1:20-1:200
-
Validations

HEK-293 cells were subjected to SDS PAGE followed by western blot with Catalog No:108365(BAX antibody) at dilution of 1:1000
Immunohistochemistry of paraffin-embedded human kidney tissue slide using Catalog No:108365(BAX Antibody) at dilution of 1:50 (under 10x lens)
Immunohistochemistry of paraffin-embedded human kidney tissue slide using Catalog No:108365(BAX Antibody) at dilution of 1:50 (under 40x lens)

IP Result of anti-BAX (IP:Catalog No:108365, 4ug; Detection:Catalog No:108365 1:1000) with HEK-293 cells lysate 1480ug.
-
Background
BAX, also named as BCL2L4, is a pro-apoptotic member of the Bcl-2 protein family, which plays a pivotal role in controlling cell life and death. Bax largely localizes to the cytoplasm of healthy cells, but accumulates on the outer mitochondrial membrane upon apoptosis induction (PMID: 9108035). BAX can commit a cell to apoptosis by translocation from the cytosol to the mitochondria and permeabilization of the outer mitochondrial membrane, which leads to the release of cytochrome c from mitochondria (PMID: 21763611). The expression of BAX is upregulated by the tumor suppressor protein p53, and BAX has been shown to be involved in p53-mediated apoptosis (PMID: 8183579).
-
References
- Xu D, Hu L, Su C. Tetrachloro-p-benzoquinone induces hepatic oxidative damage and inflammatory response, but not apoptosis in mouse: the prevention of curcumin. Toxicology and applied pharmacology. 280(2):305-13. 2014.
- Jiang SS, Weng DS, Wang QJ. Galectin-3 is associated with a poor prognosis in primary hepatocellular carcinoma. Journal of translational medicine. 12:273. 2014.
- Zhang M, Yang J, Shu J. Cytotoxicity induced by nanobacteria and nanohydroxyapatites in human choriocarcinoma cells. Nanoscale research letters. 9(1):616. 2014.
- Deng S, Tang S, Zhang S. Furazolidone induces apoptosis through activating reactive oxygen species-dependent mitochondrial signaling pathway and suppressing PI3K/Akt signaling pathway in HepG2 cells. Food and chemical toxicology : an international journal published for the British Industrial Biological Research Association. 75:173-86. 2015.
- Li X, Liu X, Xu Y, He Y, Liu J, Xie M. Expression profile of apoptotic and proliferative proteins in hypoxic HUVEC treated with statins. International journal of oncology. 46(2):677-84. 2015.
- Dai B, Wang W, Liu R, Wang H, Zhang Y. Novel taspine derivative 12k inhibits cell growth and induces apoptosis in lung cell carcinoma. Biomedicine & pharmacotherapy = Biomédecine & pharmacothérapie. 70:227-33. 2015.
- Hu L, Su C, Song X. Tetrachlorobenzoquinone triggers the cleavage of Bid and promotes the cross-talk of extrinsic and intrinsic apoptotic signalings in pheochromocytoma (PC) 12 cells. Neurotoxicology. 49:149-57. 2015.
- Dai W, Wang F, Lu J. By reducing hexokinase 2, resveratrol induces apoptosis in HCC cells addicted to aerobic glycolysis and inhibits tumor growth in mice. Oncotarget. 6(15):13703-17. 2015.
Related Products / Services
Please note: All products are "FOR RESEARCH USE ONLY AND ARE NOT INTENDED FOR DIAGNOSTIC OR THERAPEUTIC USE"
